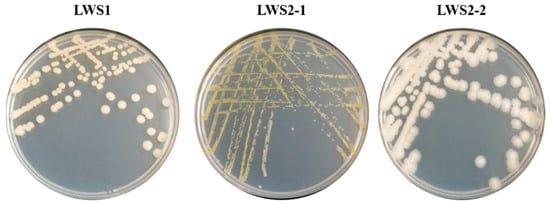

Abstract
Selenium (Se) is essential for the basic functions of life, but the low daily intake of Se urges us to find reliable ways to increase food Se content. Plant-growth-promoting bacteria (PGPB) have shown potential in enhancing plant growth and Se accumulation. In this study, the soils collected from a Se tailing were used to isolate Se-tolerant PGPB. The results showed that a total of three strains were identified. Strain LWS1, belonging to Priestia sp., grew well in M9 medium and exhibited typical PGP characteristics by an IAA-production ability of 24.3 ± 1.37 mg·L−1, siderophore-production ability of 0.23 ± 0.04 and phosphate-solubilizing ability of 87.5 ± 0.21 mg·L−1. Moreover, LWS1 strain tolerated selenite (SeIV) up to 90 mM by a LC50 of 270.4 mg·L–1. Further investigations demonstrated that the inoculation of strain LWS1 resulted in up to 19% higher biomass and 75% higher Se concentration in rice (Oryza sativa L.) than uninoculated treatments. Our study has provided evidence that microbial Se biofortification through inoculating with Priestia sp. strain LWS1 is an alternative way to improve Se uptake in crops and maintain human health.
1. Introduction
Selenium (Se) is a naturally occurring metalloid with a low concentration and uneven distribution in the earth’s crust. A typical concentration of soil Se ranges from 0.01 to 2 mg·kg−1, with an average of 0.4 mg·kg−1 [1]. Se was considered a harmful element to human beings and animals for a long time after its discovery in 1817 [2]. The turning point came through the recognition of Se’s role in preventing muscular dystrophy and liver cirrhosis in rats in 1957 [3]. We now know that the two-sided properties of Se are dependent on its intake content, and both deficiency and excessive intake are harmful to humans and animals [3]. Se deficiency has been linked to a range of health symptoms and diseases, including infertility in both men and women, miscarriage, cardiovascular disease, Keshan and Kashin–Beck disease, leukomyopathy, reduced immune function and an increased risk of various cancers [4,5,6]. Notably, excess Se intake can lead to hair loss and nervous system damage [7]. The recommended dietary allowance and tolerable upper limit of Se intake for an adult is 40 µg·day−1 and 400 µg·day−1, respectively [8]. The German, Austrian and Swiss nutrition societies have revised the reference values for the intake of Se for men by 70 µg·day−1 and for women by 60 µg·day−1 [9]. Dietary Se speciation, including seleno-aminoacids, selenocysteine, and selenomethionine, all contribute to health improvement, probably due to the catalytic role of Se in several selenoproteins such as glutathione peroxidase, thioredoxin reductase, and iodothyronine-deiodinases [3,10]. Hence, increasing food Se content is a desirable way to increase Se intake and overcome the Se-deficiency problems.
Se source foods include organ meats and seafood, muscle meats, cereal and grains, agricultural crops, milk and dairy products, and fruits and vegetables [10]. Among which, rice (Oryza sativa L.) is a staple food that sustains half of the world’s population [11], which can be an important source when increasing Se intake. Based on a daily rice consumption of 300 g·day−1, however, Williams et al. [12] revealed that 75% of the world’s rice is not enough to provide 70% of the human body’s Se needs. Se biofortification is considered to be a safe and effective method of increasing Se content in edible parts of crops, and thus increasing Se intake in the human body [13]. At present, Se biofortification in plants can be achieved by soaking seeds in Se solution, increasing soil Se concentration, foliar spray and other auxiliary methods, such as crop breeding and transgenic technology [5,14,15]. Although the application of exogenous Se can increase plant Se content, studies have shown that a high concentration of Se can inhibit plant growth. For example, when exposed to ≥5 mg·kg−1 Se, both the dry biomass and the antioxidant capacity of rice decreased [16]. Another study focusing on non-accumulator ryegrass also observed a negative relationship between solution Se and plant biomass [17]. Therefore, it is difficult to meet the requirements of biofortification with only the addition of exogenous Se.
Plant-growth-promoting bacteria (PGPB) are well-known microorganisms inhabiting the rhizosphere of plants, which can influence nutrient behaviors and plant growth via direct or indirect activities [18,19]. While biological nitrogen fixation, phosphate solubilization and phytohormone production, including indole-3-acetic acid (IAA), cytokinins and gibberellins contribute directly to plant growth, siderophore production, chitinase and glucanase production, antibiotic production, induced systematic resistance and the production of 1-aminocyclopropane-1-carboxylic acid deaminase are also important functions that regulate plant growth [19]. Of these, IAA production, siderophore production and phosphate solubilization are three indicators used to evaluate the PGP characteristics of PGPB [20]. Besides their roles in enhancing plant growth, PGPBs have also exhibited considerable effects regarding the remediation of organic- and heavy metal-contaminated soils [21,22]. For example, a recent study from Eze et al. [18] showed that the bioaugmentation with PGPB not only increased Medicago sativa biomass by 66%, but also resulted in a 91% removal of diesel hydrocarbons by an initial concentration of 4.59 mg·kg−1. The attractive applications of PGPB in promoting plant growth and heavy metal removal have also been widely documented [23,24].
As potential enhancers for Se biofortification, PGPBs have shown important benefits for Se uptake and accumulation in plants [25,26]. Among reported PGPBs, Bacillus spp. show great ability to enhance crop growth and Se accumulation. For example, by inoculating with Bacillus sp. YAM2, Yasin et al. [27] reported a promising Se biofortification strategy for wheat and potentially other crops. Given the wide use of arbuscular mycorrhizal fungi (AMF) in agricultural activities, co-inoculation of AMF with Bacillus sp. E5 also increased the Se content, chlorophyll and antioxidant enzyme content and plant biomass of lettuce [28]. Although Se is not an essential element for plants, it can benefit their growth [5,29]. As such, microbial Se fortification is a promising green way to elevate rice Se accumulation.
In the present study, we isolated a new Se-tolerant bacterial strain and evaluated its potential roles in promoting rice growth and Se accumulation. The full objectives were (1) identify the Se-tolerant ability of the newly isolated bacterial strain LWS1, (2) test the PGP characteristics of strain LWS1 and (3) evaluate the potential roles of strain LWS1 in plant growth and Se accumulation in rice. We believe that the results have provided a new bioresource, with potential use in promoting plant growth and Se accumulation in rice.
2. Materials and Methods
2.1. Microbial Screening and Identification
The soil used for bacterial isolation was collected from a Se-mine in Longyan, Fujian, China. Half of the collected soil was stored at −80 °C for 12 h and freeze-dried for 48 h till a balance weight was reached (Labconco FreeZone 6 plus, Kansas City, MI, USA). The soils were ground and sieved to <2 mm, and finally digested using the USEPA method 3050B [30]. The concentrations of typical heavy metal(loid)s were (mg·kg−1): 9.38 ± 0.17 (Se), 12.1 ± 0.21 (arsenic, As), 0.46 ± 0.06 (cadmium, Cd), 24.1 ± 0.53 (lead, Pb), 69.4 ± 1.39 (zinc, Zn) and 21.8 ± 2.16 (copper, Cu).
To isolate Se-tolerant bacteria, about 0.5 g of fresh soil was washed thrice with sterile phosphate-buffered solution (PBS, prepared by 19 mL 0.2 M NaH2PO4 and 81 mL 0.2 M Na2HPO4, pH 7.4) [31], followed by incubation in Luria–Bartani (LB) medium spiked with 100 mg·L−1 selenite (SeIV, Na2SeO3). The incubation conditions were 30 °C and 150 rpm for 12 h. The bacterial suspension was sub-cultured 3–5 times in a new medium to enrich the Se-tolerant bacteria. After a continuous gradient dilution, 50 μL of the established suspensions was spread on LB agar medium spiked with 100 mg·L−1 SeIV and incubated in an incubator at 30 °C until apparent colonies occurred. Each colony with a different morphology was picked out and re-incubated in LB and LB agar medium to obtain pure isolates. The suspension of each isolate was finally mixed with an equivalent volume of 50% glycerol and stored at −80 °C before further identification.
All isolates were re-incubated in LB medium at 30 °C and 150 rpm for 12 h. Aliquots of enriched suspensions were used to extract bacterial total DNA using a FastDNA® SPIN Kit for Soil (MP Biomedicals, LLC, 9 Goddard Irvine, CA, USA) according to the manufacturer’s instructions [30]. In our study, the 16S rRNA gene for each isolate was amplified by PCR with the universal primers 5′-AGAGTTTGATCCTGGCTCAG-3′ (BACT27F) and 5′-ACGGCTACCTTGTTACGACTT-3′ (PROK1492R) on a T100 Thermocycler (Bio-Rad, 1000 Alfred Nobel Drive Hercules, CA, USA). The PCR mixtures consisted of 12.5 μL of 2 × Mix (Yifeixue Biotechnology, Nanjing, China), 1.5 μL of 10 μM mixed primer pair, 10 μL of PCR degrade water and 1 μL of DNA template with a normalized concentration of 50 ng·μL−1. The PCR programs included pre-denaturation (5 min at 94 °C), denaturation (35 s at 94 °C), annealing (30 s at 55 °C) and extension (1.5 min at 72 °C). The PCR cycles were 35 with a final extension at 72 °C for 10 min. Following an electrophoresis verification by 2% agarose gel, the PCR products were purified and sequenced by Allwegene Tech. (Beijing, China). The obtained sequences were analyzed by BLAST similarity search against the known sequences in NCBI database. Finally, the phylogenetic tree of 16S rRNA gene was constructed by MEGA 5.0 using the Neighbor-Joining algorithm. The nucleotide sequence of 16S rRNA gene of strain LWS1 was deposited in GenBank with the accession number of ON377339.
2.2. Analysis of Se Tolerance
To test Se tolerance, strain LWS1 was first incubated in LB medium at 30 °C and 150 rpm for 12 h. The established bacterial suspensions were centrifuged at 5000× g for 5 min to obtain biomass, which was then washed three times with PBS spiked with 0.9% NaCl. In our study, the Se-tolerant experiment was performed in M9 medium due to its clear components and lower interference in metabolism inside bacterial cells compared to LB medium. More details about M9 medium are available from Jouanneau et al. [32]. In brief, aliquots of the established bacterial suspensions were transferred to M9 medium to make the final OD600 of 0.01. The concentrations of solution SeIV were 0, 7.5, 15, 37.5, 75, 150, 375, 750, 1500, 3750 and 7500 mg·L−1. After 24 h of incubation, the OD600 of strain LWS1 was recorded to evaluate bacterial growth. To obtain a further evaluation of Se tolerance in strain LWS1, a nonlinear fitting based on the logistic model by using OriginPro 2021 (OriginLab Corporation, Northampton, MA, USA) was also performed. As a result, the median lethal dose (LC50) of Se to bacterial strain was obtained.
2.3. Characterization of PGP Traits
The abilities of IAA biosynthesis, siderophore biosynthesis and phosphate solubilization can be regarded as typical indicators for PGP characteristics [20]. To evaluate the potential roles of strain LWS1 in regulating rice growth, the above-mentioned indexes were fully determined. Before characterization, the strain was incubated in LB medium at 30 °C and 150 rpm for 12 h. The biomass was collected by centrifugation at 5000× g for 5 min and re-suspended in sterile Milli-Q water to a uniform OD600 value. Aliquots of the resuspensions were transferred to following media for the analysis of PGP traits. The treatments without bacterial inoculation and with the inoculation of PGP strain Pseudomonas sp. PVR02 [33] were set as negative and positive controls, respectively.
To characterize the IAA biosynthesis ability of strain LWS1, 0.2 mL diluted suspension with OD600 = 1.5 was added into 20 mL sucrose minimal salts (SMS) medium [34]. The components of SMS medium include 10 g·L−1 sucrose, 2 g·L−1 K2HP4, 1 g·L−1 (NH4)2SO4, 0.5 g·L−1 MgSO4, 0.5 g·L−1 yeast extract, 0.5 g·L−1 CaCO3, 0.1 g·L−1 NaCl and 0.5 g·L−1 L-tryptophan (pH = 7.2). The strain was incubated at 30 °C and 150 rpm for 4 d, followed by centrifugation at 8000× g for 15 min. Finally, 1 mL of the supernatant was mixed with 2 mL Salkowski reagent consisting of 50 mL 35% HClO4 and 1 mL 0.5 M FeCl3. Following a stationary reaction for 40 min in the dark at room temperature, a pink color developed in the supernatant suspensions [34]. The absorbance of pink color was read at 530 nm. The IAA concentration was determined using a calibration curve of pure IAA as a standard following the linear regression analysis [23].
According to Schwyn and Neilands [35], the chrome azurol-S (CAS) analytical method was used to identify siderophore production ability. In briefy 0.2 mL bacterial suspension with OD600 = 1.5 was incubated in modified sucrose-aspartic acid medium, which contains 20 g·L−1 sucrose, 2 g·L−1 aspartic acid, 1 g·L−1 K2HP4 and 0.5 g·L−1 MgSO4·7H2O with a pH of 7.0. The strain was incubated at 30 °C and 150 rpm for 2 d and centrifugated at 8000× g for 15 min. The supernatant was mixed with 1 mL CAS solution. A uninoculated medium was used as a blank control. After 3 h incubation in the dark at room temperature, the OD630 was measured and the siderophore production capacity was calculated as sample OD630/control OD630 (λ/λ0).
Regarding phosphate-solubilizing ability, the strain was incubated in National Botanical Research Institute’s phosphate (NBRIP) growth medium [36]. The medium was composed of 5 g·L−1 glucose, 5 g·L−1 MgCl2·6H2O, 0.25 g·L−1 MgSO4·7H2O, 0.2 g·L−1 KCl, 0.1 g·L−1 (NH4)2SO4 and 5 g·L−1 Ca3(PO4)2 with a total volume of 20 mL and a pH of 7.0 ± 0.2. After an incubation at 30 °C and 150 rpm for 8 d, the suspensions were centrifuged at 8000× g for 15 min. The soluble phosphate was determined by the modified molybdenum blue method at 880 nm. In brief, 5 mL of the supernatants was collected and mixed with 0.5 mL of 10% (m/v) ascorbic acid and incubated for 30 s. A total of 1 mL of color developing agent (45 mL of 14% (m/v) ammonium molybdate solution + 5 mL of 3% (m/v) antimony potassium tartrate solution + 200 mL of 6 mol·L−1 H2SO4) was then added into the mixture and incubated for 15 min. Finally, the soluble phosphate concentration in the samples was calculated using a standard curve of pure phosphate solution following the linear regression analysis [37].
2.4. Evaluation of the Effects of Strain LWS1 on Plant Growth and Se Accumulation in Rice
Agricultural topsoil (0–15 cm) was collected from Fuzhou, China. The soils were air-dried and sieved to <2 mm before use. Different concentrations of SeIV-contaminated soils (0, 0.125, 0.175, 0.425, 3 and 6 mg·kg−1 of soil) were prepared by spiking 2.5 kg of soils with appropriate amounts of Na2SeO3. According to Eze et al. [38,39], the spiked soils were first mixed manually by hand wearing gloves, then thoroughly mixed using an IBC portable electric mixer (IBC H003). The mixing was performed for 15 min with a break and manual shaking after every 5 min to achieve complete homogeneity [39]. The homogenized soils were then aged for one month to make the soil system stable [40]. In brief, the soils were brought to 50% water-holding capacity and stored in a dark room to mimic the field drying–wetting cycles. Moreover, the plastic bags used to hold soils were partially opened for aeration.
The rice seeds of cultivar Yiyou 673 were soaked in sterile Milli-Q water for 1 h and disinfected by 75% ethanol for 30 s and 30% NaClO for 30 min. The absorbed chemical agents were removed following a thorough wash by sterile Milli-Q water. All seeds were geminated in a greenhouse under a light photoperiod of 16 h, a light density of 350 μmol·m−1·s−1, mean temperature of 25 °C and relative humidity of 70%, according to Xu et al. [41]. Rice plants with 2–3 leaves, of ~5 cm in height, were transferred to the aged soils in plastic pots, which contained 2.5 kg soils with a water depth of 3 cm. Before the experiment, strain LWS1 was activated in LB medium at 30 °C, 150 rpm for 12 h. Following centrifugation at 5000× g for 5 min, the obtained biomass was washed three times by sterile PBS and finally resuspended in sterile Milli-Q water to a uniform concentration. In each pot, 10 mL of bacterial suspension (1.2 × 107 cfu·mL−1) was added each month to the root base of rice plant. A treatment without bacterial inoculation was also set as control. The rice plants were grown in a greenhouse with the same conditions as described before.
After 4 months of growth, all rice plants were harvested and divided into root, husk, leaf and grain. The plant biomass was weighed and recorded. All plant tissues were freeze-dried for 48 h and digested according to USEPA method 3050B [30]. After centrifuging at 8000× g for 15 min, the supernatant was filtered by a 0.45 μm filter and diluted as required. In our study, the Se concentration was determined by graphite furnace atomic absorption spectroscopy (GFAAS). The instrument parameters used in the determination of Se were a wavelength of 196.0 nm, lamp current of 15 mA, slit width of 0.2 nm and sample volume of 20 μL, while the graphite furnace program for Se determination included 4 steps: drying at 120 °C for a ramp time of 55 s and hold time of 5 s, pyrolysis at 1400 °C for a ramp time of 10 s and hold time of 6 s, atomization at 2400 °C for a ramp time of 0 s and hold time of 2 s, and cleaning at 2700 °C for a ramp time of 1 s and hold time of 2 s [42]. Se stock solution (1000 μg·mL−1) purchased from the National Center for Standard Substances (Beijing, China) was diluted as necessary to establish the reference curve.
2.5. Statistical Analyses
All the experiments were conducted in four replicates. The data are presented as the mean value with standard error. Significant differences were determined according to two-way analysis of variance (ANOVA) by Tukey’s multiple comparisons test at p ≤ 0.05 using GraphPad Prism (Release 6.0, La Jolla, CA, USA).
3. Results and Discussion
3.1. Three Se-Tolerant Strains Were Isolated from Se Tailing Soil
Following a multiple enrichment in LB medium spiked with 100 mg·L−1 SeIV, a total of three culturable bacterial strains were isolated (Figure 1). While all strains formed a regular colony, only strain LWS1 had a flat colony structure (Figure 1). Moreover, the colony of strain LWS2-1 was yellow, but both LWS1 and LWS2-2 were of a white color (Figure 1). The colony morphology revealed that the three isolates belong to different microbial species. However, only strain LWS1 could grow well in M9 medium spiked with 100 mg·kg−1 Se. Considering that a flexible adaptability to complex inhabitants is an important trait for bacterial environmental applications [43], strain LWS1, which can grow in M9 medium with simple components, was further identified by 16S rRNA gene amplification and consequent evolutionary position analysis.
Figure 1.
The colony morphology of the three bacterial strains isolated from Se tailing soil. The strains were grown on LB agar medium containing 100 mg·L−1 SeIV.
To further identify the taxonomic level of strain LWS1, its 16S rRNA gene sequence was aligned with the known sequences retrieved from the NCBI database. As shown in Figure 2, the 16S rRNA gene of strain LWS1 shared high similarity with several species of the genus Bacillus, with the highest BLAST scores (100%) observed in Bacillus sp. (in: Bacteria) IC-1C2 (MT649293.1). Compared with previous studies, the colony morphology of strain LWS1 showed the typical properties of B. megaterium [44], which was recently reclassified as Priestia megaterium [45]. Therefore, we preliminarily speculated that the bacterium was a new strain of Priestia, namely, Priestia sp. strain LWS1.

Figure 2.
Neighbor-Joining phylogenetic tree of 16S rRNA sequence of strain LWS1 and reference sequences retrieved from NCBI database based on similarity analysis. The BLAST parameters included an expected threshold: 10, word size: 28, max matches in a query range: 0, match/mismatch scores: −1 and −2, gap costs: linear, filter: low-complexity regions and mask: lookup table only. The tree root was constructed with bootstrap values calculated from 1000 resamplings. The numbers at each node indicate the percentage of bootstrap supporting. The scale bar represents 10 substitutions per 100 bases. The sequence alignment and the phylogenic tree construction were performed by MEGA 6.0.
3.2. Strain LWS1 Showed Great Se Tolerance
To obtain an overview of the tolerance of B. megaterium to Se, strain LWS1 was exposed to different SeIV concentrations ranging from 0 to 7500 mg·L−1. In general, strain LWS1 grew well in M9 medium spiked with ≤37.5 mg·L−1 Se, and the corresponding OD600 was between 1.938 and 2.215 (Figure 3A). The OD600 significantly decreased to 1.873 (p < 0.05) at 75 mg·L−1 Se (Figure 3A). When exposed to 375 mg·L−1 Se, the 57% growth in strain LWS1 was inhibited (p < 0.01; Figure 3A). In this study, the initial inoculating amount of strain LWS1 was recorded as OD600 = 0.01, and a considerable OD600 of 0.108 at a Se concentration of 7500 mg·L−1 suggested that strain LWS1 could tolerate a high concentration of Se (Figure 3A). A logistic fitting revealed a typical correlation between solution Se concentration and OD600 by a LC50 of 270.4 mg L−1 (R2 = 0.9938, p < 0.01; Figure 3B).

Figure 3.
Se resistance of strain LWS1 grown in M9 medium containing SeIV for 24 h. Bacterial growth under different concentrations of Se from 0 to 7500 mg·L−1 (A) and logistic fitting to calculate the LC50 of Se to strain LWS1 (B). Different letters indicate significant differences between treatments based on two-way ANOVA by Tukey’s multiple comparisons test at p ≤ 0.05.
Microbes are key drivers influencing Se behaviors in the environment [46]. Bacterial tolerance to Se was widely reported in recent studies. P. megaterium (formerly B. megaterium) is a well-known bacteria, capable of great tolerance to Se. One possible process associated with Se tolerance in P. megaterium can be the reduction in SeIV to elemental Se [47], which can be supported by its potential use in the biosynthesis of Se nanoparticles [48,49]. Studies have also investigated the transformation of P. megaterium in the oxidation of elemental Se to SeIV [50]. However, there has been limited information regarding Se’s inhibitory effect on P. megaterium and the response of P. megaterium to Se stress to date. Moreover, the reported strains of P. megaterium could tolerate both SeIV and selenate (SeVI), and the maximum inhibitory concentration (MIC) of SeIV was significantly lower than that observed in LWS1 [47,50]. Regarding other species in the genus Bacillus, B. fusiformis ARI 3, Bacillus sp. ARI 6 and B. sphaericus ARI 8 isolated from Se-contaminated soils had a MIC up to 450–600 μM for SeIV and 650–700 μM for SeVI [51]. However, several endobacteria, such as Klebsiella spp., Bacillus spp. and Acinetobacter sp., reported by Durán et al. [52] exhibited a surprising Se tolerance ability, with the MIC reaching 180 mM (SeIV). A similar finding was also found in Kuar et al. [53], where 80 mM Se only decreased the biomass of fungi Fusarium equiseti (SeF5) by about 30%. It is worth noting that, due to the lower toxicity of SeVI as compared to SeIV, microbes often show higher resistance to SeVI (Table 1). For example, P. megaterium CHP08, Bacillus sp. CHP07 and Paenibacillus favisporus CHP14 could tolerate a SeVI as high as 200–450 mM [54]. Our data suggested that strain LWS1 showed a great ability to tolerate Se stress like other reported Se-tolerant microbes.

Table 1.
Se-tolerance ability and PGP characteristics of the representative microbes reported previously.
3.3. Strain LWS1 Exhibited Typical PGP Characteristics
As previously noted, PGP characteristics are important in agricultural applications, especially in aiding plant growth and Se accumulation in crops [26,28,52]. As can be seen in Table 1, strain LWS1 was able to synthesize IAA and siderophore, and solubilize Ca3(PO4)2 to sustain phosphorus acquisition. Specifically, strain LWS1 produced IAA by 24.3 ± 1.37 mg·L−1, which is comparable to other reported bacteria (Table 1). In genus Bacillus, strain LWS1 showed a higher ability to produce IAA than strains CHP08 (11.5 ± 3.5 mg·L−1) and YAM2 (12 mg·L−1) [27,54]. It seems that microbial IAA production ability is associated with Se tolerance. For example, those microbes, such as Bacillus sp. E6.1, F. equiseti SeF5 and Klebsiella sp. E2, which tolerated Se up to 180 mM, also produced a higher IAA ranging from 39.9 to 94.1 mg·L−1 (Table 1). One explanation is that the production of IAA and the resistance to several heavy metals such as Se, tellurium and lead are probably relevant due to the associated genes often dispersing on the same plasmid [55]. Unlike IAA, the biosynthesis of siderophores is not a universal trait for Se-tolerant microbes (Table 1). To date, studies have found that bacterial siderophores can form stable complexes with lots of metals, including Fe, As, Al, Cd, Cu, Ga, In, Pb, and Zn, as well as the radionuclides including U and Np [20,56]. The siderophore-mediated Al uptake by P. megaterium ATCC 19213 was well-documented by Hu and Boyer [57]. Regarding Priestia sp. Strain LWS1, the siderophore-producing ability, present as λ/λ0, was 0.23 ± 0.04 (Table 1). This indicated that strain LWS1 had a lower siderophore-producing ability than Se-tolerant fungi F. equiseti SeF5 by λ/λ0 = 0.155, but this ability was higher than that observed in Pseudopestaloti opsistheae by 0.317 (Table 1). As noted by the criteria for siderophore-producing ability, strain LWS1 showed a strong ability to produce siderophores (Table 1).
It was interesting to note that strain LWS1 harbored the most efficient phosphate-solubilizing ability, i.e., 87.5 ± 0.21 mg·L−1, in the representative microbial strains with a given Se tolerance (Table 1). The phosphate-solubilizing ability of Priestia sp. Strain LWS1 was higher than that of the P. megaterium strain HCP08 by 58.8 ± 24.1 mg·L−1 and Paenibacillus favisporus CHP14 by 27.6 ± 11.5 mg·L−1 isolated from the Se-hyperaccumulating plant Cardamine hupingshanensis [54]. In conclusion, strain LWS1 is a typical PGPB with IAA- and siderophore-production abilities and phosphate-solubilization abilities, which can be used as a potential enhancer to regulate plant growth.
3.4. Strain LWS1 Enhanced Plant Growth and Se Accumulation in Rice
After 4 months of growth, the dry biomass of different tissues of rice plant was recorded. In control treatments without bacterial inoculation, the root, husk, leaf and grain biomass of rice grown in the soils spiked with different Se concentrations ranged from 2.73 ± 0.45 g to 3.42 ± 0.30 g (Figure 4A), from 4.35 ± 0.43 g to 5.93 ± 0.59 g (Figure 4B), from 2.39 ± 0.18 g to 2.88 ± 0.25 g (Figure 4C) and from 4.16 ± 0.09 g to 4.92 ± 0.21 g (Figure 4D), respectively. However, the plant biomass in each treatment did not follow a typical trend. This can also be observed by the result for the total dry biomass of rice plant (Figure 4E). Our data were different from Dai et al. [16] in that the plant height, dry biomass, 1000-grain weight and rice yield all positively correlated to soil Se concentrations ranging from 0 to 5 mg·kg–1. In fact, the role of Se in plant growth remains controversial and whether Se is essential for plants is yet to be established [5]. For the treatments inoculated with strain LWS1, however, the root, husk, leaf and total biomass of rice plants grown in Se-spiked soils obtained a larger biomass than the control (Figure 4). The highest difference could be observed for root biomass of 40% in group Se0.425, for husk biomass of 12% in group Se0.175, for leaf biomass of 41% in group Se0.125 and for total biomass of 6% in group Se0.175 (Figure 4). By comparing the two treatments with or without bacterial inoculation, the presence of strain LWS1 exhibited typical enhancements of plant growth. The significant increase in the root, husk, leaf, grain and total biomass of rice plant reached up to 47% (Se0.425 in Figure 4A; p < 0.01), 51% (Se0.175 in Figure 4B; p < 0.01), 63% (Se0.125 in Figure 4C; p < 0.01), 17% (Se6 in Figure 4D; p < 0.05) and 19% (Se0.175 in Figure 4E; p < 0.05), respectively. It was apparent that both bacteria and Se contributed to rice growth, but Se-enhanced plant growth was dependent on the presence of strain LWS1.

Figure 4.
Dry weight of the root biomass (A), husk biomass (B), leaf biomass (C), grain biomass (D) and total biomass (E) of rice plant with or without the inoculation of strain LWS1 (n = 4). The plants were grown in soils spiked with 0–6 mg·kg–1 SeIV. Different letters indicate significant differences between treatments based on two-way ANOVA by Tukey’s multiple comparisons test at p ≤ 0.05.
To verify whether plant growth was associated with Se, we also tested Se concentration in different tissues of rice. As shown in Figure 5, unlike plant biomass, Se concentration in all tissues of rice without PGPB inoculation dramatically increased with the increase in soil Se. The root was the tissue accumulating most of the assimilated Se (Figure 5A), followed by husk (Figure 5B), with the lowest Se concentration observed in the leaf (Figure 5C) and grain (Figure 5D) of rice. The results were in accordance with previous research [16]. Similar to uninoculated treatments, the plant Se concentration in inoculated treatments also increased with the increase in soil Se, as did the Se distribution pattern in different rice tissues (Figure 5). The comparisons between uninoculated and inoculated treatments showed that bacterial inoculation increased plant Se by 12–106% in the root, 2.5–65% in the husk, 17–47% in the leaf and 16–47% in the grain (Figure 5). However, bacterial inoculation only significantly increased the root Se (1.92 ± 0.19 vs. 2.35 ± 0.24; p < 0.01) of rice when grown in the soils spiked with 6 mg·kg–1 Se (Figure 5A). Our data suggested that plant Se concentration was not correlated with plant biomass (Figure 4 and Figure 5), suggesting the leading role of PGPB in promoting plant growth. In other words, the increase of Se accumulation in rice might be an indirect result of LWS1-mediated plant growth.

Figure 5.
Se concentrations in the root biomass (A), husk biomass (B), leaf biomass (C), grain biomass (D) and total biomass (E) of rice plants with or without the inoculation of strain LWS1 (n = 4). The plants were grown in the soils spiked with 0–6 mg·kg–1 SeIV. Different letters indicate significant differences between treatments based on two-way ANOVA by Tukey’s multiple comparisons test at p ≤ 0.05.
In recent decades, several studies have focused on the use of P. megaterium to promote plant growth and remediation of heavy-metals-contaminated media, which is probably associated with its PGP characteristics and heavy-metal tolerance [58,59,60]. For example, a study from Rajkumar et al. [24] identified P. megaterium SR28C as a PGPB strain involved in the plant growth of Brassica juncea, Luffa cylindrica and Sorghum halepense and their tolerance to Ni stress. Similar to strain SR28C, endophytic P. megaterium BM18-2 has also shown dual roles in regulating Cd resistance and promoting plant growth [61]. Although P. megaterium is a well-known beneficial bacterium that has been industrially employed for more than 65 years [62], its application in the biofortification of plant growth and Se accumulation in rice is still limitedly documented. Our data suggested that PGPB and Se might play a synergistic role in enhancing plant growth and the involvement of beneficial PGPB was helpful for Se biofortification in rice [26]. However, bacterial inoculation had not significantly elevated Se accumulation in rice (Figure 5), indicating that other factors in the complex system (i.e., soil-microbe-plant system) also contributed to Se behaviors in the rhizosphere of rice and its translocation from the soils to the plants. As such, more details on the roles of Priestia sp. LWS1 in promoting plant growth and Se accumulation in rice still warrant future investigations.
4. Conclusions
In this study, a typical PGPB strain, namely Priestia sp. LWS1 was isolated from a Se tailing soil. Strain LWS1 could produce IAA by 24.3 ± 1.37 mg·L−1, produce siderophore by 0.23 ± 0.04, solubilize phosphate by 87.5 ± 0.21 mg·L−1 and tolerate SeIV by up to 90 mM. The inoculation of strain LWS1 lead to the significant promotion of plant growth, but strain LWS1 might only one of the regulators in enhancing Se accumulation in rice. Our data shed light onto the potential use of Priestia sp. in Se biofortification in crops and improving Se-deficiency in human beings.
Author Contributions
Conceptualization, Y.-H.H. and S.-S.W.; Data curation, X.-R.L., H.-B.C., J.-B.L., Y.-H.H. and S.-S.W.; Funding acquisition, Y.-H.H.; Investigation, H.-B.C., Y.-H.H. and S.-S.W.; Methodology, X.-R.L., Y.-X.L., H.-B.C. and Y.-H.H.; Supervision, Y.-H.H. and S.-S.W.; Writing—original draft, X.-R.L., Y.-H.H. and S.-S.W.; Writing—review and editing, X.-R.L., H.-B.C., Y.-X.L., Z.-H.Z., J.-B.L., Y.-Q.W., H.Z., Y.Z., Y.-H.H. and S.-S.W. All authors have read and agreed to the published version of the manuscript.
Funding
This work was supported by the National Natural Science Foundation of China (41807110), the National Natural Science Foundation of Fujian Province (2021J01196), the Education Department Fund of Fujian Province (JAT170144), Undergraduate Education and Teaching Reform Research Project of Fujian Normal University and the Research Start-up Fund of Fujian Normal University (Y0720304x13).
Institutional Review Board Statement
Not applicable.
Informed Consent Statement
Not applicable.
Data Availability Statement
The data presented in this study are available upon request from the corresponding author.
Conflicts of Interest
The authors declare no conflict of interest.
References
- Hartikainen, H. Biogeochemistry of selenium and its impact on food chain quality and human health. J. Trace Elem. Med. Biol. 2005, 18, 309–318. [Google Scholar] [CrossRef] [PubMed]
- Lemly, A.D. Environmental implications of excessive selenium: A review. Biomed. Environ. Sci. 1997, 10, 415–435. [Google Scholar] [PubMed]
- Gupta, M.; Gupta, S. An overview of selenium uptake, metabolism, and toxicity in plants. Front. Plant Sci. 2017, 7, 2074. [Google Scholar] [CrossRef] [PubMed]
- Mistry, H.D.; Pipkin, F.B.; Redman, C.W.G.; Poston, L. Selenium in reproductive health. Am. J. Obstet. Gynecol. 2012, 206, 21–30. [Google Scholar] [CrossRef]
- Sarwar, N.; Akhtar, M.; Kamran, M.A.; Imran, M.; Riaz, M.A.; Kamran, K.; Hussain, S. Selenium biofortification in food crops: Key mechanisms and future perspectives. J. Food Compos. Anal. 2020, 93, 103615. [Google Scholar] [CrossRef]
- Ullah, H.; Liu, G.; Yousaf, B.; Ali, M.U.; Irshad, S.; Abbas, Q.; Ahmad, R. A comprehensive review on environmental transformation of selenium: Recent advances and research perspectives. Environ. Geochem. Health 2019, 41, 1003–1035. [Google Scholar] [CrossRef]
- Vleet, J.F.V.; Ferrans, V.J. Etiologic factors and pathologic alterations in selenium-vitamin E deficiency and excess in animals and humans. Biol. Trace Elem. Res. 1992, 33, 1–21. [Google Scholar] [CrossRef]
- Zhang, H.; Feng, X.; Chan, H.M.; Larssen, T. New insights into traditional health risk assessments of mercury exposure: Implications of selenium. Environ. Sci. Technol. 2014, 48, 1206–1212. [Google Scholar] [CrossRef]
- Kipp, A.P.; Strohm, D.; Brigelius-Flohé, R.; Schomburg, L.; Bechthold, A.; Leschik-Bonnet, E.; Heseker, H.; German Nutrition Society (DGE). Revised reference values for selenium intake. J. Trace Elem. Med. Bio. 2015, 32, 195–199. [Google Scholar] [CrossRef]
- Rayman, M.P. Selenium and human health. Lancet 2012, 379, 1256–1268. [Google Scholar] [CrossRef]
- Chen, Y.; Han, Y.-H.; Cao, Y.; Zhu, Y.-G.; Rathinasabapathi, B.; Ma, L.Q. Arsenic transport in rice and biological solutions to reduce arsenic risk from rice. Front. Plant Sci. 2017, 8, 268. [Google Scholar] [CrossRef] [PubMed]
- Williams, P.N.; Lombi, E.; Sun, G.-X.; Scheckel, K.; Zhu, Y.-G.; Feng, X.; Zhu, J.; Carey, A.-M.; Adomako, E.; Lawgali, Y.; et al. Selenium characterization in the global rice supply chain. Environ. Sci. Technol. 2009, 43, 6024–6030. [Google Scholar] [CrossRef] [PubMed]
- Zhang, L.; Shi, W.; Wang, X. Difference in selenite absorption between high-and low-selenium rice cultivars and its mechanism. Plant Soil 2006, 282, 183–193. [Google Scholar] [CrossRef]
- Zhu, Y.-G.; Pilon-Smits, E.A.H.; Zhao, F.-J.; Williams, P.N.; Meharg, A.A. Selenium in higher plants: Understanding mechanisms for biofortification and phytoremediation. Trends Plant Sci. 2009, 14, 436–442. [Google Scholar] [CrossRef] [PubMed]
- Schiavon, M.; Nardi, S.; Vecchia, F.d.; Ertani, A. Selenium biofortification in the 21st century: Status and challenges for healthy human nutrition. Plant Soil 2020, 453, 245–270. [Google Scholar] [CrossRef]
- Dai, Z.; Imtiaz, M.; Rizwan, M.; Yuan, Y.; Huang, H.; Tu, S. Dynamics of Selenium uptake, speciation, and antioxidant response in rice at different panicle initiation stages. Sci. Total Environ. 2019, 691, 827–834. [Google Scholar] [CrossRef]
- Versini, A.; Di Tullo, P.; Aubry, E.; Bueno, M.; Thiry, Y.; Pannier, F.; Castrec-Rouelle, M. Influence of Se concentrations and species in hydroponic cultures on Se uptake, translocation and assimilation in non-accumulator ryegrass. Plant Physiol. Bioch. 2016, 108, 372–380. [Google Scholar] [CrossRef]
- Eze, M.O.; Thiel, V.; Hose, G.C.; George, S.C.; Daniel, R. Enhancing rhizoremediation of petroleum hydrocarbons through bioaugmentation with a plant growth-promoting bacterial consortium. Chemosphere 2022, 289, 133143. [Google Scholar] [CrossRef]
- Goswami, D.; Thakker, J.N.; Dhandhukia, P.C. Portraying mechanics of plant growth promoting rhizobacteria (PGPR): A review. Cogent. Food Agric. 2016, 2, 1127500. [Google Scholar] [CrossRef]
- Rajkumar, M.; Ae, N.; Prasad, M.N.V.; Freitas, H. Potential of siderophore-producing bacteria for improving heavy metal phytoextraction. Trends Biotechnol. 2010, 28, 142–149. [Google Scholar] [CrossRef]
- Grandlic, C.J.; Mendez, M.O.; Chorover, J.; Machado, B.; Maier, R.M. Plant growth-promoting bacteria for phytostabilization of mine tailings. Environ. Sci. Technol. 2008, 42, 2079–2084. [Google Scholar] [CrossRef] [PubMed]
- Khan, S.; Afzal, M.; Iqbal, S.; Khan, Q.M. Plant–bacteria partnerships for the remediation of hydrocarbon contaminated soils. Chemosphere 2013, 90, 1317–1332. [Google Scholar] [CrossRef] [PubMed]
- Jiang, C.-y.; Sheng, X.-f.; Qian, M.; Wang, Q.-y. Isolation and characterization of a heavy metal-resistant Burkholderia sp. from heavy metal-contaminated paddy field soil and its potential in promoting plant growth and heavy metal accumulation in metal-polluted soil. Chemosphere 2008, 72, 157–164. [Google Scholar] [CrossRef] [PubMed]
- Rajkumar, M.; Ma, Y.; Freitas, H. Improvement of Ni phytostabilization by inoculation of Ni resistant Bacillus megaterium SR28C. J. Environ. Manag. 2013, 128, 973–980. [Google Scholar] [CrossRef] [PubMed]
- Yang, D.; Hu, C.; Wang, X.; Shi, G.; Li, Y.; Fei, Y.; Song, Y.; Zhao, X. Microbes: A potential tool for selenium biofortification. Metallomics 2021, 13, mfab054. [Google Scholar] [CrossRef]
- Ye, Y.; Qu, J.; Pu, Y.; Rao, S.; Xu, F.; Wu, C. Selenium biofortification of crop food by beneficial microorganisms. J. Fungi 2020, 6, 59. [Google Scholar] [CrossRef]
- Yasin, M.; El-Mehdawi, A.F.; Anwar, A.; Pilon-Smits, E.A.H.; Faisal, M. Microbial-enhanced selenium and iron biofortification of wheat (Triticum aestivum L.)-Applications in phytoremediation and biofortification. Int. J. Phytoremediat. 2015, 17, 341–347. [Google Scholar] [CrossRef]
- Durán, P.; Acuña, J.J.; Armada, E.; López-Castillo, O.M.; Cornejo, P.; Mora, M.L.; Azcón, R. Inoculation with selenobacteria and arbuscular mycorrhizal fungi to enhance selenium content in lettuce plants and improve tolerance against drought stress. J. Soil Sci. Plant Nutr. 2016, 16, 201–225. [Google Scholar] [CrossRef][Green Version]
- White, P.J. Selenium metabolism in plants. BBA Gen. Subj. 2018, 1862, 2333–2342. [Google Scholar] [CrossRef]
- Han, Y.-H.; Yin, D.-X.; Jia, M.-R.; Wang, S.-S.; Chen, Y.; Rathinasabapathi, B.; Chen, D.-L.; Ma, L.Q. Arsenic-resistance mechanisms in bacterium Leclercia adecarboxylata strain As3-1: Biochemical and genomic analyses. Sci. Total Environ. 2019, 690, 1178–1189. [Google Scholar] [CrossRef]
- Wang, S.-S.; Ye, S.-L.; Han, Y.-H.; Shi, X.-X.; Chen, D.-L.; Li, M. Biosorption and bioaccumulation of chromate from aqueous solution by a newly isolated Bacillus mycoides strain 200AsB1. RSC Adv. 2016, 6, 101153–101161. [Google Scholar] [CrossRef]
- Jouanneau, Y.; Meyer, C.; Duraffourg, N. Dihydroxylation of four- and five-ring aromatic hydrocarbons by the naphthalene dioxygenase from Sphingomonas CHY-1. Appl. Microbiol. Biotechnol. 2016, 100, 1253–1263. [Google Scholar] [CrossRef] [PubMed]
- Xu, J.-Y.; Han, Y.-H.; Chen, Y.; Zhu, L.-J.; Ma, L.Q. Arsenic transformation and plant growth promotion characteristics of As-resistant endophytic bacteria from As-hyperaccumulator Pteris vittata. Chemosphere 2016, 144, 1233–1240. [Google Scholar] [CrossRef] [PubMed]
- Gordon, S.A.; Weber, R.P. Colorimetric estimation of indoleacetic acid. Plant Physiol. 1951, 26, 192–195. [Google Scholar] [CrossRef]
- Schwyn, B.; Neilands, J. Universal chemical assay for the detection and determination of siderophores. Anal. Biochem. 1987, 160, 47–56. [Google Scholar] [CrossRef]
- Nautiyal, C.S. An efficient microbiological growth medium for screening phosphate solubilizing microorganisms. FEMS Microbiol. Lett. 1999, 170, 265–270. [Google Scholar] [CrossRef]
- Watanabe, F.S.; Olsen, S.R. Test of an ascorbic acid method for determining phosphorus in water and NaHCO3 extracts from soil. Soil Sci. Soc. Am. J. 1965, 29, 677–678. [Google Scholar] [CrossRef]
- Eze, M.O.; George, S.C.; Hose, G.C. Dose-response analysis of diesel fuel phytotoxicity on selected plant species. Chemosphere 2021, 263, 128382. [Google Scholar] [CrossRef]
- Eze, M.O.; Hose, G.C.; George, S.C. Assessing the effect of diesel fuel on the seed viability and germination of Medicago sativa using the event-time model. Plants 2020, 9, 1062. [Google Scholar] [CrossRef]
- Liang, S.; Guan, D.-X.; Ren, J.-H.; Zhang, M.; Luo, J.; Ma, L.Q. Effect of aging on arsenic and lead fractionation and availability in soils: Coupling sequential extractions with diffusive gradients in thin-films technique. J. Hazard. Mater. 2014, 273, 272–279. [Google Scholar] [CrossRef]
- Xu, J.-Y.; Li, H.-B.; Liang, S.; Luo, J.; Ma, L.Q. Arsenic enhanced plant growth and altered rhizosphere characteristics of hyperaccumulator Pteris vittata. Environ. Pollut. 2014, 194, 105–111. [Google Scholar] [CrossRef] [PubMed]
- Aleixo, P.C.; Nóbrega, J.A. Direct determination of iron and selenium in bovine milk by graphite furnace atomic absorption spectrometry. Food Chem. 2003, 83, 457–462. [Google Scholar] [CrossRef]
- Bao, M.-T.; Wang, L.-N.; Sun, P.-Y.; Cao, L.-X.; Zou, J.; Li, Y.-M. Biodegradation of crude oil using an efficient microbial consortium in a simulated marine environment. Mar. Pollut. Bull. 2012, 64, 1177–1185. [Google Scholar] [CrossRef] [PubMed]
- Zhou, J.; Ma, Q.; Yi, H.; Wang, L.; Song, H.; Yuan, Y.-J. Metabolome profiling reveals metabolic cooperation between Bacillus megaterium and Ketogulonicigenium vulgare during induced swarm motility. Appl. Environ. Microbiol. 2011, 77, 7023–7030. [Google Scholar] [CrossRef] [PubMed]
- Hossain, T.J.; Das, M.; Ali, F.; Chowdhury, S.I.; Zedny, S.A. Substrate preferences, phylogenetic and biochemical properties of proteolytic bacteria present in the digestive tract of Nile tilapia (Oreochromis niloticus). AIMS Microbiol. 2021, 7, 528–545. [Google Scholar] [CrossRef] [PubMed]
- Masscheleyn, P.H.; Patrick, W.H., Jr. Biogeochemical processes affecting selenium cycling in wetlands. Environ. Toxicol. Chem. 1993, 12, 2235–2243. [Google Scholar] [CrossRef]
- Mishra, R.R.; Prajapati, u.; Das, J.; Dangar, T.K.; Das, N.; Thatoi, H. Reduction of selenite to red elemental selenium by moderately halotolerant Bacillus megaterium strains isolated from Bhitarkanika mangrove soil and characterization of reduced product. Chemosphere 2011, 84, 1231–1237. [Google Scholar] [CrossRef]
- Hashem, A.H.; Abdelaziz, A.M.; Askar, A.A.; Fouda, H.M.; Khalil, A.M.A.; Abd-Elsalam, K.A.; Khaleil, M.M. Bacillus megaterium-mediated synthesis of selenium nanoparticles and their antifungal activity against Rhizoctonia solani in faba bean plants. J. Fungi 2021, 7, 195. [Google Scholar] [CrossRef]
- Ramamurthy, C.; Sampath, K.S.; Arunkumar, P.; Kumar, M.S.; Sujatha, V.; Premkumar, K.; Thirunavukkarasu, C. Green synthesis and characterization of selenium nanoparticles and its augmented cytotoxicity with doxorubicin on cancer cells. Bioproc. Biosyst. Eng. 2013, 36, 1131–1139. [Google Scholar] [CrossRef]
- Sarathchandra, S.U.; Watkinson, J.H. Oxidation of elemental selenium to selenite by Bacillus megaterium. Science 1981, 211, 600–601. [Google Scholar] [CrossRef]
- Ghosh, A.; Mohod, A.M.; Paknikar, K.M.; Jain, R.K. Isolation and characterization of selenite- and selenate-tolerant microorganisms from selenium-contaminated sites. World J. Microbiol. Biotechnol. 2008, 24, 1607–1611. [Google Scholar] [CrossRef]
- Durán, P.; Acuña, J.J.; Jorquera, M.A.; Azcón, R.; Paredes, C.; Rengel, Z.; de la Luz Mora, M. Endophytic bacteria from selenium-supplemented wheat plants could be useful for plant-growth promotion, biofortification and Gaeumannomyces graminis biocontrol in wheat production. Biol. Fert. Soils 2014, 50, 983–990. [Google Scholar] [CrossRef]
- Kaur, T.; Vashisht, A.; Prakash, N.T.; Reddy, M.S. Role of selenium-tolerant fungi on plant growth promotion and selenium accumulation of maize plants grown in seleniferous soils. Water Air Soil Pollut. 2022, 233, 17. [Google Scholar] [CrossRef]
- Li, Q.; Zhou, S.; Liu, N. Diversity of endophytic bacteria in Cardamine hupingshanensis and potential of culturable selenium-resistant endophytes to enhance seed germination under selenate stress. Curr. Microbiol. 2021, 78, 2091–2103. [Google Scholar] [CrossRef] [PubMed]
- Huddedar, S.B.; Shete, A.M.; Tilekar, J.N.; Gore, S.D.; Dhavale, D.D.; Chopade, B.A. Isolation, characterization, and plasmid pUPI126-mediated indole-3-acetic acid production in Acinetobacter strains from rhizosphere of wheat. Appl. Biochem. Biotechnol. 2002, 102, 21–39. [Google Scholar] [CrossRef]
- Ghosh, P.; Rathinasabapathi, B.; Teplitski, M.; Ma, L.Q. Bacterial ability in AsIII oxidation and AsV reduction: Relation to arsenic tolerance, P uptake, and siderophore production. Chemosphere 2015, 138, 995–1000. [Google Scholar] [CrossRef]
- Hu, X.; Boyer, G.L. Siderophore-mediated Al uptake by Bacillus megaterium ATCC 19213. Appl. Environ. Microbiol. 1996, 62, 4044–4048. [Google Scholar] [CrossRef]
- Njokua, K.L.; Akinyede, O.R.; Obidi, O.F. Microbial remediation of heavy metals contaminated media by Bacillus megaterium and Rhizopus stolonifer. Sci. Afr. 2020, 10, e00545. [Google Scholar] [CrossRef]
- Zou, C.; Li, Z.; Yu, D. Bacillus megaterium strain XTBG34 promotes plant growth by producing 2-pentylfuran. J. Microbiol. 2010, 48, 460–466. [Google Scholar] [CrossRef]
- Chakraborty, U.; Chakraborty, B.; Basnet, M. Plant growth promotion and induction of resistance in Camellia sinensis by Bacillus megaterium. J. Basic Microbiol. 2006, 46, 186–195. [Google Scholar] [CrossRef]
- Wu, J.; Kamal, N.; Hao, H.; Qian, C.; Liu, Z.; Shao, Y.; Zhong, X.; Xu, B. Endophytic Bacillus megaterium BM18-2 mutated for cadmium accumulation and improving plant growth in Hybrid Pennisetum. Biotechnol. Rep. 2019, 24, e00374. [Google Scholar] [CrossRef] [PubMed]
- Vary, P.S.; Biedendieck, R.; Fuerch, T.; Meinhardt, F.; Rohde, M.; Deckwer, W.-D.; Jahn, D. Bacillus megaterium—from simple soil bacterium to industrial protein production host. Appl. Microbiol. Biotechnol. 2007, 76, 957–967. [Google Scholar] [CrossRef] [PubMed]
Publisher’s Note: MDPI stays neutral with regard to jurisdictional claims in published maps and institutional affiliations. |
© 2022 by the authors. Licensee MDPI, Basel, Switzerland. This article is an open access article distributed under the terms and conditions of the Creative Commons Attribution (CC BY) license (https://creativecommons.org/licenses/by/4.0/).